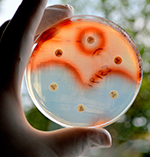

| Broadcast Date | Image | Episode Title | Episode # |
|---|---|---|---|
| Feb 17, 2017 |
 Image for Pet Yeasts
Image for Pet Yeasts
|
Pet Yeasts | 535 |
| Feb 10, 2017 |
 Image for The Island of Dr. Moreau for Real
Image for The Island of Dr. Moreau for Real
|
The Island of Dr. Moreau for Real | 534 |
| Feb 3, 2017 |
 Image for Ringing in Young Ears
Image for Ringing in Young Ears
|
Ringing in Young Ears | 533 |
| Jan 27, 2017 |
 Image for Why Include Both Sexes in Studies
Image for Why Include Both Sexes in Studies
|
Why Include Both Sexes in Studies | 532 |
| Jan 20, 2017 |
 Image for Lots of Different Neurons
Image for Lots of Different Neurons
|
Lots of Different Neurons | 531 |
| Jan 13, 2017 |
 Image for Zombie Genes
Image for Zombie Genes
|
Zombie Genes | 530 |
| Jan 6, 2017 |
 Image for The King of Cloning Is Fading
Image for The King of Cloning Is Fading
|
The King of Cloning Is Fading | 529 |
| Dec 30, 2016 |
 Image for 2016 Nobel Prizes
Image for 2016 Nobel Prizes
|
2016 Nobel Prizes | 528 |
| Dec 23, 2016 |
 Image for Spit Makes It Worse
Image for Spit Makes It Worse
|
Spit Makes It Worse | 527 |
| Dec 16, 2016 |
 Image for Is Mary Jane Bad for Your Health?
Image for Is Mary Jane Bad for Your Health?
|
Is Mary Jane Bad for Your Health? | 526 |
| Dec 9, 2016 |
 Image for A Sweet Dream
Image for A Sweet Dream
|
A Sweet Dream | 525 |
| Dec 2, 2016 |
 Image for Tumors Make Their Own Blood Vessels
Image for Tumors Make Their Own Blood Vessels
|
Tumors Make Their Own Blood Vessels | 524 |
| Nov 25, 2016 |
 Image for A Blood Test to Help Choose an Antidepressant
Image for A Blood Test to Help Choose an Antidepressant
|
A Blood Test to Help Choose an Antidepressant | 523 |
| Nov 18, 2016 |
 Image for Cancer Detection in a Breath
Image for Cancer Detection in a Breath
|
Cancer Detection in a Breath | 522 |
| Nov 11, 2016 |
 Image for Factors Accelerating the Spread of Infectious Diseases
Image for Factors Accelerating the Spread of Infectious Diseases
|
Factors Accelerating the Spread of Infectious Diseases | 521 |
| Nov 4, 2016 |
 Image for Opioids Can Extend Pain
Image for Opioids Can Extend Pain
|
Opioids Can Extend Pain | 520 |
| Oct 28, 2016 |
 Image for Alzheimer's - Could the Brain Be Trying to Protect Us?
Image for Alzheimer's - Could the Brain Be Trying to Protect Us?
|
Alzheimer's - Could the Brain Be Trying to Protect Us? | 519 |
| Oct 21, 2016 |
 Image for Genes That Protect the Heart
Image for Genes That Protect the Heart
|
Genes That Protect the Heart | 518 |
| Oct 14, 2016 |
 Image for Jet Dryers Spread Microbes
Image for Jet Dryers Spread Microbes
|
Jet Dryers Spread Microbes | 517 |
| Oct 7, 2016 |
 Image for A New Era for GMOs
Image for A New Era for GMOs
|
A New Era for GMOs | 516 |
| Sep 30, 2016 |
 Image for Cholesterol Sweet Spot
Image for Cholesterol Sweet Spot
|
Cholesterol Sweet Spot | 515 |
| Sep 23, 2016 |
 Image for Hello Syn
Image for Hello Syn
|
Hello Syn | 514 |
| Sep 16, 2016 |
 Image for A Top 10 List Waiting to Save Lives
Image for A Top 10 List Waiting to Save Lives
|
A Top 10 List Waiting to Save Lives | 513 |
| Sep 9, 2016 |
 Image for Giving a Face to Penicillin
Image for Giving a Face to Penicillin
|
Giving a Face to Penicillin | 512 |
| Sep 2, 2016 |
 Image for Autism Causes
Image for Autism Causes
|
Autism Causes | 511 |
| Aug 26, 2016 |
 Image for See Like a Dolphin
Image for See Like a Dolphin
|
See Like a Dolphin | 510 |
| Aug 19, 2016 |
 Image for A Good Night's Sleep
Image for A Good Night's Sleep
|
A Good Night's Sleep | 509 |
| Aug 12, 2016 |
 Image for A New Patient Zero
Image for A New Patient Zero
|
A New Patient Zero | 508 |
| Aug 5, 2016 |
 Image for Genetics and the Unibrow
Image for Genetics and the Unibrow
|
Genetics and the Unibrow | 507 |
| Jul 29, 2016 |
 Image for Custom Printed Organs
Image for Custom Printed Organs
|
Custom Printed Organs | 506 |
| Jul 22, 2016 |
 Image for Cocaine and HIV Infection
Image for Cocaine and HIV Infection
|
Cocaine and HIV Infection | 505 |
| Jul 15, 2016 |
 Image for Sleep - Good for the Waistline
Image for Sleep - Good for the Waistline
|
Sleep - Good for the Waistline | 504 |
| Jul 8, 2016 |
 Image for Tracking Human Migration on a Micro Scale
Image for Tracking Human Migration on a Micro Scale
|
Tracking Human Migration on a Micro Scale | 503 |
| Jul 1, 2016 |
 Image for Knocking Out ALL
Image for Knocking Out ALL
|
Knocking Out ALL | 502 |
| Jun 24, 2016 |
 Image for A Mercurial Toxin
Image for A Mercurial Toxin
|
A Mercurial Toxin | 501 |
| Jun 17, 2016 |
 Image for Too Much of a Good Thing
Image for Too Much of a Good Thing
|
Too Much of a Good Thing | 500 |
| Jun 10, 2016 |
 Image for Restoring the Microbiome of C-Section Babies
Image for Restoring the Microbiome of C-Section Babies
|
Restoring the Microbiome of C-Section Babies | 499 |
| Jun 3, 2016 | Image not found for this episode | An Immune System Reboot for MS | 498 |
| May 27, 2016 |
 Image for A Potential Public Health Nightmare
Image for A Potential Public Health Nightmare
|
A Potential Public Health Nightmare | 497 |
| May 20, 2016 |
 Image for The Zoo We Bear
Image for The Zoo We Bear
|
The Zoo We Bear | 496 |
| May 13, 2016 |
 Image for When Cancer Glows
Image for When Cancer Glows
|
When Cancer Glows | 495 |
| May 6, 2016 |
 Image for Kratom: Treating Addiction With Addiction
Image for Kratom: Treating Addiction With Addiction
|
Kratom: Treating Addiction With Addiction | 494 |
| Apr 22, 2016 |
 Image for Ancient Brain Surgery
Image for Ancient Brain Surgery
|
Ancient Brain Surgery | 492 |
| Apr 15, 2016 |
 Image for Molecular Surgery
Image for Molecular Surgery
|
Molecular Surgery | 491 |
| Apr 8, 2016 |
 Image for The Rise of Zika
Image for The Rise of Zika
|
The Rise of Zika | 490 |
| Apr 1, 2016 |
 Image for Sleeping With Ebola
Image for Sleeping With Ebola
|
Sleeping With Ebola | 489 |
| Mar 25, 2016 |
 Image for The Snake Was Framed
Image for The Snake Was Framed
|
The Snake Was Framed | 488 |
| Mar 18, 2016 |
 Image for Second Hand Smoke and Allergies in Kids
Image for Second Hand Smoke and Allergies in Kids
|
Second Hand Smoke and Allergies in Kids | 487 |
| Mar 11, 2016 |
 Image for New Gene Therapy Lights Up Vision
Image for New Gene Therapy Lights Up Vision
|
New Gene Therapy Lights Up Vision | 486 |
| Mar 4, 2016 |
Image for The Global Threat of Antibiotic Resistance
Image for The Global Threat of Antibiotic Resistance
|
The Global Threat of Antibiotic Resistance | 485 |
| Feb 26, 2016 |
 Image for The First Happy Hour
Image for The First Happy Hour
|
The First Happy Hour | 484 |
| Feb 19, 2016 |
 Image for Understanding Pain
Image for Understanding Pain
|
Understanding Pain | 483 |
| Feb 12, 2016 |
 Image for Defeating Prostate Cancer
Image for Defeating Prostate Cancer
|
Defeating Prostate Cancer | 482 |
